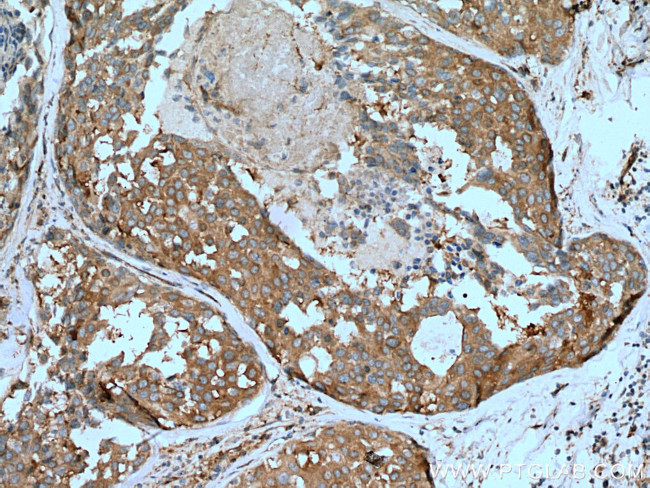
NEDD4 Antibody in Immunohistochemistry (Paraffin) (IHC (P))
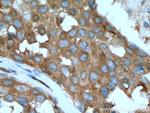
NEDD4 Antibody in Immunohistochemistry (Paraffin) (IHC (P))
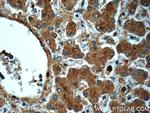
NEDD4 Antibody in Immunohistochemistry (Paraffin) (IHC (P))

Search
Proteintech
NEDD4 Polyclonal Antibody
{{$productOrderCtrl.translations['antibody.pdp.commerceCard.promotion.promotions']}}
{{$productOrderCtrl.translations['antibody.pdp.commerceCard.promotion.viewpromo']}}
{{$productOrderCtrl.translations['antibody.pdp.commerceCard.promotion.promocode']}}: {{promo.promoCode}} {{promo.promoTitle}} {{promo.promoDescription}}. {{$productOrderCtrl.translations['antibody.pdp.commerceCard.promotion.learnmore']}}
产品信息
21698-1-AP
种属反应
已发表种属
宿主/亚型
分类
类型
抗原
偶联物
形式
浓度
规格
纯化类型
保存液
内含物
保存条件
运输条件
产品详细信息
This antibody can recognize NEDD4-1 and NEDD4-2.
Immunogen sequence: TVLEDSYRR IMGVKRADFL KARLWIEFDG EKGLDYGGVA REWFFLISKE MFNPYYGLFE YSATDNYTLQ INPNSGLCNE DHLSYFKFIG RVAGMAVYHG KLLDGFFIRP FYKMMLHKPI TLHDMESVDS EYYNSLRWIL ENDPTELDLR FIIDEELFGQ THQHELKNGG SEIVVTNKNK KEYIYLVIQW RFVNRIQKQM AAFKEGFFEL IPQDLIKIFD ENELELLMCG LGDVDVNDWR EHTKYKNGYS ANHQVIQWFW KAVLMMDSEK RIRLLQFVTG TSRVPMNGFA ELYGSNGPQS FTVEQWGTPE KLPRAHTCFN RLDLPPYESF EELWDKLQMA IENTQGFDGV D (970-1319 aa encoded by BC152452)
靶标信息
The E3 ubiquitin-protein ligase NEDD4 is a Ubl conjugation pathway protein. It contains one HECT (E6AP-type E3 ubiquitin-protein ligase) domain and four WW domains. It is involved in the pathway leading to the degradation of VEGFR-2/KDFR, independently of its ubiquitin-ligase activity. It acts as a potential proto-oncogene that negatively regulates PTEN via ubiquitination, a paradigm analogous to that of Mdm2 and p53. It is also reported to be involved in the budding of many viruses and is the regulator of epithelial Na+ channels, which lead to arterial hypertension. NEDD4 protein is localized to the sarcolemmal region of muscle fibers. Increase in NEDD4 protein expression leads to unloaded and denervated muscles as well as a decrease in Notch1 expression. Hence it acts as down regulator of Notch-1 gene expression.
仅用于科研。不用于诊断过程。未经明确授权不得转售。
生物信息学
蛋白别名: Cell proliferation-inducing gene 53 protein; E3 ubiquitin-protein ligase NEDD4; HECT-type E3 ubiquitin transferase NEDD4; KIAA0093; NEDD-4; Neural precursor cell expressed developmentally down-regulated protein 4; neural precursor cell expressed, developmentally down-regulated 4, E3 ubiquitin protein ligase; neural precursor cell expressed, developmentally down-regulated gene 4; neural precursor cell expressed, developmentally down-regulated gene 4A; neural precursor cell expressed, developmentally down-regulted gene 4; OTTHUMP00000217840; OTTHUMP00000217841; OTTHUMP00000217842; PIG53; receptor-potentiating factor 1; unnamed protein product
基因别名: AA959633; AL023035; AU019897; E430025J12Rik; KIAA0093; mKIAA0093; Nedd-4; NEDD4; NEDD4-1; Nedd4a; PIG53; RPF1
UniProt ID: (Human) P46934, (Rat) Q62940, (Mouse) P46935
Entrez Gene ID: (Human) 4734, (Rat) 25489, (Mouse) 17999